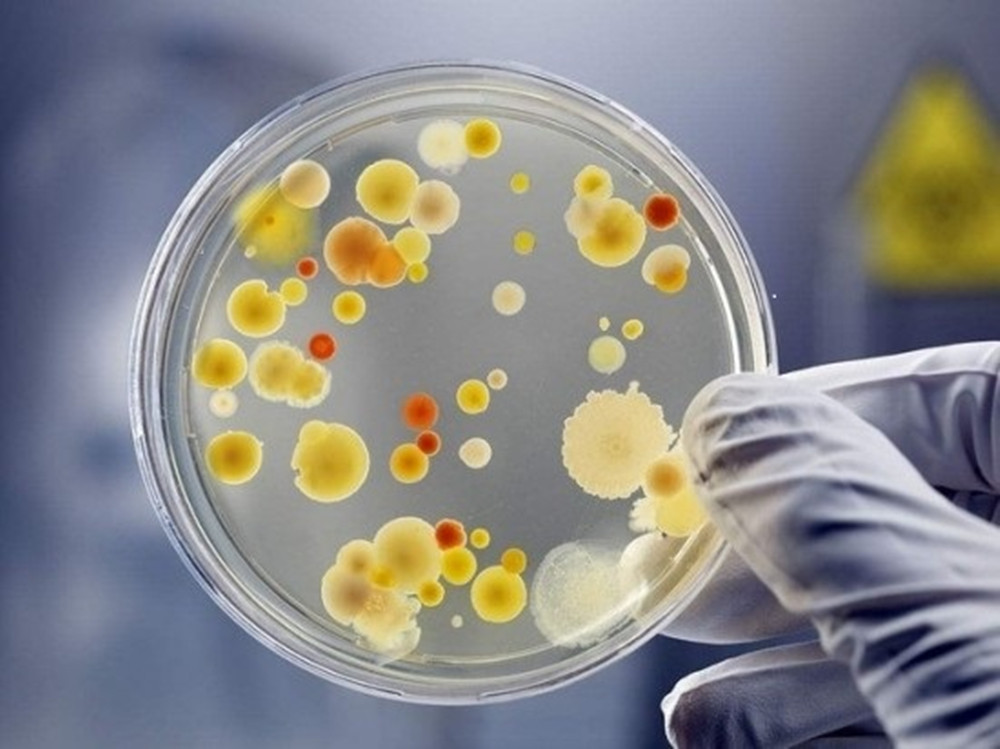
冰箱里面冰怎样铲掉,冰箱结冰怎么快速铲冰

最近卷毛看到很多粉丝的留言,发现大家很容易会走入一个误区,为什么食材放入冰箱之前还有做这么多的保护工作和措施,简简单单的保鲜袋一裹,打开冰箱一丢一关万事大吉!其实这样的想法真的是不正确的,冰箱只能为我们的食材提供低温的环境,压制细菌的发育,减慢食材腐败变质的速度。但不是说可以杀菌!明白吗?它不是消毒柜。
放在冰箱里面的食材没有妥当的包裹,会发生串味的情况。食材腐败变质的速度也不同,会导致细菌局部空间的蔓延,生鲜和熟食我们都需要分开存放,特别是大热天的时候,很多人都喜欢装一杯水,放到冷藏柜中冰冻一下再喝,然后常常容易拉肚子。是因为杯没有很好的密封起来,导致冰箱内一些细菌跑入水中,那我们人体喝了,肯定是爱拉肚子的。

所以我们要有定期清理冰箱的习惯才是最好的,保持室内环境的干净,无异味。今天邻居老人家刚好摆脱卷毛,去为他家的冰箱除冰呀,那就顺便教大家一个生活小技巧了。
冰箱之所以会结冰,那就是冰箱门的密封胶老化了,软胶条变硬导致关门的时候,无法做到无缝贴合。导致外部的空气容易进入到冰箱中,冰箱不停地加冻,空气中的水分不断地凝结,往往会不到一段时间,冰冻层的厢壁上结上一层厚厚的冰块,严重的时候连冷藏层也会结冰。

遇到这种情况的时候很多朋友,都会直接拔掉电源,将冰箱内部食材全部取出,把冰箱门打开,让它自然解冻脱落。这个解冻的过程耗时会稍微有点长,往往是冰箱水流到满地都是,非常不方便。还有就是食材取出来的时间过长,导致温差快速的变化,很容易吸收水分,会加速食材的变质。有些朋友会使用比较*力暴**的手段电源一拔,直接上工具开始敲打冰块,生拉硬扯将冰块给撬下来,但是这样一不小心就会损坏到冰箱内壁,得不偿失。

今天卷毛给大家支一招,能让冰块可以简单快速脱落的,连女生都可以轻轻松松,优雅地将冰块取下。我们先烧开一大壶水,用上一个大小适中的面盆或者大碗也行,将开水倒入盆中,这里可以撒入适量的食用盐!盐也是一个除冰的小能手哦。然后把冰箱内部所有食材取出,电源断掉,把盛满盐开水的盆放入冰箱冰冻层中,关上冰箱门。这时啥都不用管了,爱干嘛就干嘛去,溜达个五分钟,如果结冰严重的就溜达个十分钟。记得这期间千万不要打开冰箱门。

时间到,可以开门啦!缓缓将冰箱门打开,嘿,你就会很神奇地发现,冰块已经自己脱落了,还有开始融化的迹象。其实冰箱就是一个密封保温的箱子,可以保持冰度又可以保持热度。将盐开水放到冰箱内部,它的水汽会不断散发,热度也一直外溢,不断地在冰箱内部填充热度,这时冰块就能够快速解冻,脱落下来。这时我们需要做的就是将冰块取出吗,把冰箱内部用干净的擦布把多余的水分擦拭掉。也可以用盐水擦拭一下,这样能起到很好的杀菌作用。

冰箱处理干净之后,记得要将食材分类包裹好,生熟食要分开区间,最后再放入一卷纸巾或者半个柠檬,柚子皮吸附异味就妥妥的啦。不知道各位朋友平时有没遇到冰箱结冰的难题,对你们有起到帮助的话,记得关注卷毛我哦!今天的分享就到这里,谢谢大家。